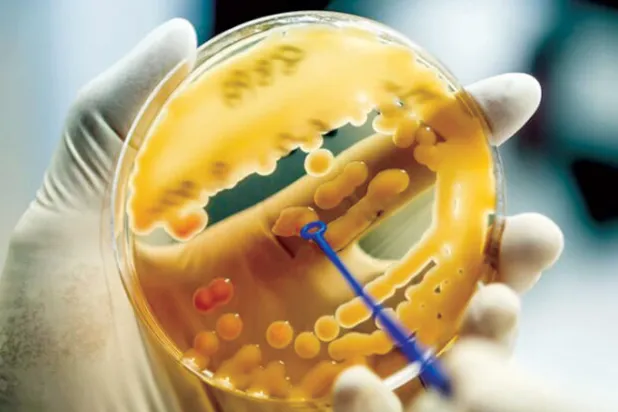
بكتيريا الكلبسيلة الرئوية حيرت العلماء لعقود

سويسرا أخبار
سويسرا أخبار
وجد باحثو المعهد الفيدرالي للتكنولوجيا في زيوريخ بسويسرا، أن مجموعة من البروتينات لها أشكال مختلفة في السائل النخاعي للأفراد الأصحاء، مقارنة بمرضى باركنسون «الشلل الرعاش»، وأعلنوا في دراسة نشرت (الأحد) بدورية «علم الأحياء الهيكلية والجزيئية الطبيعة»، أنه يمكن استخدام هذه البروتينات في المستقبل كنوع جديد من العلامات الحيوية لهذا المرض. ويمكن اكتشاف العديد من الأمراض البشرية وتشخيصها باستخدام العلامات الحيوية في الدم أو سوائل الجسم الأخرى، ولكن حتى الآن لا يوجد لمرض باركنسون، مثل هذه العلامات الحيوية، للإشارة إلى هذا المرض التنكسي العصبي، لكن الفريق البحثي بقيادة باولا بيكوتي، أخذ خطوة متقدمة في
ربما يخوض منتخب البرازيل (بطل العالم سابقاً 5 مرات) مباراته المقبلة في المجموعة السابعة في كأس العالم 2022 لكرة القدم في قطر، في مواجهة سويسرا، غداً الاثنين، من دون لاعب الوسط لوكاس باكيتا. وتأكد بالفعل غياب النجم البرازيلي نيمار عن المواجهة، وكذلك الظهير الأيمن دانيلو، بسبب إصابتهما في الكاحل خلال الفوز 2-صفر، في مباراة الفريق الأولى أمام صربيا. وتدرب المنتخب البرازيلي المرشح للتتويج بلقب البطولة خلف أبواب مغلقة في «استاد العربي» أمس السبت، ولم يكشف المدرب تيتي عن أي تفاصيل عن تشكيلة الفريق، خلال مؤتمره الصحافي، اليوم الأحد. لكن «رويترز» علمت أن باكيتا لم يتمكن من التدرب بصورة كاملة، وكان لهذ
أعربت كبيرة العلماء في منظمة الصحة العالمية عن أسفها إزاء تعامل المنظمة المبكر مع وباء «كورونا»، وفقاً لصحيفة «إندبندنت». فقد كشفت سمية سواميناثان (63 عاماً)، أنه كان ينبغي على منظمة الصحة العالمية أن تعترف، في وقت سابق، بأن «كوفيد - 19» يمكن أن ينتقل من خلال الهباء الجوي. وقالت لـ«ساينس إنسايدر»: «كان يجب أن نفعل ذلك في وقت مبكر، بناء على الأدلة المتاحة، وهو أمر كلّف المنظمة... يمكنك القول إن (انتقاد منظمة الصحة العالمية) غير عادل، لأنه عندما يتعلق الأمر بهجرة الفيروس، تحدثنا بالفعل عن جميع الأساليب، بما في ذلك التهوئة والأقنعة».
دشّنت الكاميرون عودتها إلى نهائيات كأس العالم لكرة القدم، بخسارة أمام سويسرا بهدف سجّله «ابنها» بريل إمبولو الخميس على ملعب الجنوب في الوكرة، في الجولة الأولى من منافسات المجموعة السابعة ضمن مونديال قطر 2022. وسجل إمبولو، الكاميروني الأصل والمولود في العاصمة ياوندي، الهدف الوحيد في الدقيقة 48 وبدا متأثراً ولم يحتفل. وتلعب لاحقاً البرازيل مع صربيا ضمن المجموعة ذاتها. وغابت الكاميرون التي تشارك في النهائيات للمرة الثامنة في تاريخها، عن النسخة الأخيرة في روسيا، ومُنيت بخسارتها الثامنة توالياً والثالثة عشرة في 24 مباراة. في المقابل، حققت سويسرا التي تخوض العرس العالمي للمرة الثانية عشرة والخامسة ت
وجه جياني إنفانتينو رئيس الاتحاد الدولي لكرة القدم سلسلة من الانتقادات اللاذعة للدول الأوروبية، مؤكداً أنه لا يجب أن تقدم الدروس الأخلاقية للعرب ولقطر تحديدا وذلك في تعليقاته خلال المؤتمر الصحافي الذي عقده أمس في الدوحة قبل يوم من انطلاق كأس العالم المقرر في قطر. وقال إنفانتينو «أنا هنا ليس لإعطائكم دروسا في الحياة، لكن ما يحصل في الوقت الحالي هنا ليس عادلا على الإطلاق.
دفع الاستخدام غير المعقول للمضادات الحيوية البكتيريا لتطوير آليات مقاومة لهذا النوع من العلاج، وهي الظاهرة، المعروفة باسم «مقاومة المضادات الحيوية»، والتي تعتبرها منظمة الصحة العالمية، واحدة من أكبر التهديدات للصحة، حيث يمكن أن يعيدنا نقص العلاج ضد البكتيريا المقاومة، إلى زمن مات فيه ملايين الأشخاص بسبب الالتهاب الرئوي أو السالمونيلا. وتعد بكتيريا «الكلبسيلة الرئوية»، وهي شائعة جداً في المستشفيات وخبيثة بشكل خاص، أحد مسببات الأمراض التي أصبحت أسلحتنا ضدها غير حادة، غير أن فريقا بحثيا من جامعة جنيف، اكتشف جزيئا مضادا للهربس يستخدم منذ الستينيات، يضعف السطح الوقائي لهذه البكتيريا ويسهل للخلايا ا
في حدث أقيم بمناسبة الذكرى السنوية الـ175 لإنشاء نظام السكك الحديدية السويسرية، تم تشكيل أطول قطار ركاب في العالم أول من أمس (السبت) في جبال الألب السويسرية، يضم مجموعة من مائة عربة، بطول إجمالي يقرب من كيلومترين، حسب وكالة الصحافة الفرنسية. وكانت قد، أعلنت شركة السكك الحديدية المحلية (Rhaetian Railway Company (RhB أنها حطمت الرقم القياسي العالمي لأطول قطار للركاب. واجتاز القطار الذي يبلغ طوله 1910 أمتار، والمكون من 25 قطاراً مجمعاً، مسافة 25 كيلومتراً في أقل من 45 دقيقة بين بريدا وألفانيو في كانتون غراوبوندن السويسري. وقال مدير شركة السكك الحديد ريناتو فاسياتي لصحيفة «بليك» المحلية «بالنسبة ل
من المتوقع أن يتوجه الكثير من عشاق السكك الحديدية إلى سويسرا، في وقت لاحق من أكتوبر (تشرين الأول)، ليشهدوا تسجيل رقم قياسي عالمي جديد لأطول قطار ركاب في العالم، وذلك عبر جبال الألب السويسرية، حسب وكالة الأنباء الألمانية (د.ب.أ). وتعتزم سكك حديد «ريشن» السويسرية، في 29 من شهر أكتوبر (تشرين الأول)، تشغيل قطار يبلغ طوله 1.9 كيلومتر، في رحلة تستغرق مُدتها ساعة، تسير على طول ممر «ألبولا» الشهير، بين المناظر الطبيعية في منطقة «جراوبوندين» لمسافة 25 كيلومتراً تقريباً. وتتطلب العملية، التي تُعدّ في حد ذاتها إنجازاً هندسياً للسكك الحديدية، 7 من سائقي القطارات و21 فنياً؛ لتشغيل ما يصل إلى 100 من العربات
أعلنت مؤسسة «مورغان ستانلي» الأميركية للخدمات المالية والمصرفية، أن الساعات الشهيرة المستعملة مثل «رولكس» و«باتيك فيليب» و«أوديمار بيجيه» ستشهد تراجعاً في أسعارها بسبب كثرة المعروض في الأسواق. وفق «وكالة الأنباء الألمانية». وذكرت «وكالة بلومبرغ للأنباء» أنه منذ ارتفاع الأسعار خلال عام 2021 والربع الأول من العام الحالي، تراجعت أسعار معظم أنواع الساعات الشهيرة مثل «رولكس» بنسبة 21 في المائة، منذ بلوغ الأسعار ذروتها في أبريل (نيسان) الماضي، حسب مؤشر «ووتش شارتس» لقياس أسعار الساعات الشهيرة.
ربحت شركة صناعة الشوكولا السويسرية «لينت أند شبرونغلي» جولة من نزاعها القضائي في سويسرا مع الفرع المحلي لسلسلة محال السوبر ماركت «ليدل» في شأن أرانب عيد الفصح، إذ اعتبرت المحكمة الفدرالية أن تلك التي تنتجها شبكة المتاجر تشكّل خطر التباس. وقضت المحكمة الفيدرالية السويسرية في قرار أصدرته الخميس بأن أرنب الشوكولا الذي تنتجه «ليندت» والملفوف بورق الألمنيوم «الذهبي أو بلون آخر» يجب أن يحظى بحماية ماركة مودعة ضد المنتج المنافس من «ليدل». ونص القرار على منع الفرع السويسري لشبكة متاجر السوبر ماركت الذي يحمل اسم «ليدل شفايتز إيه جي» و«ليدل شفايتز دي إل إيه جي»، من أن يبيع في متاجره أرنبه ذا الشكل المشا
تراجع الفرنك السويسري لأدنى مستوى منذ 2015 مقابل اليورو بعدما أثبت قيام «البنك الوطني السويسري» بزيادة معدل الفائدة بواقع 75 نقطة أساس أنه غير كاف لإرضاء توقعات المتعاملين، بحسب وكالة «بلومبرغ» للأنباء. وتراجعت العملة بنسبة 1.8 في المائة لتصل 96.81 سنتيم لكل يورو بعدما رفع «البنك الوطني السويسري» سعر الفائدة الرئيسي إلى 0.5 في المائة، مثلما توقع خبراء الاقتصاد. وامتص الفرنك قدراً من التراجع بعد أن أعلن رئيس البنك، توماس جوردان، أن البنك المركزي سوف يدرس اتخاذ قرارات مؤقتة إذا تحتم الأمر. وما زال البعض يرون هذا انتكاسة مؤقتة للعملة، التي وصلت لأعلى مستوى خلال 7 أعوام مقابل اليورو، في وقت مبكر م
قال العالم الدنماركي رينيه فورسبرج لوكالة الأنباء الألمانية أمس (الجمعة) إن ما كان يعتقد أنها جزيرة في أقصى شمال العالم، ليست جزيرة على الإطلاق وإنما جبل جليدي مغطى بالتراب والحصى. واكتشف علماء دنماركيون وسويسريون الجبل الجليدي الذي كانوا يعتقدون أنه جزيرة، شمال غرينلاند العام الماضي.
بدأت الاثنين محاكمة امرأة سويسرية تعاني من مشاكل عقلية بتهمة ارتكاب «عمل إرهابي» لمحاولتها ذبح امرأتين بينما كانت تهتف بنصرة النبي محمد في متجر كبير في لوغانو في عام 2020. وفي 24 نوفمبر (تشرين الثاني) 2020 صعدت المتهمة التي كان عمرها آنذاك 28 عاماً، إلى الطابق الخامس المخصص لبيع مواد التنظيف في متجر «مانور دو لوغانو» في المنطقة الناطقة بالإيطالية وطلبت استفساراً من عاملة لشراء سكين للخبز واختارت شفرة مسننة يبلغ طولها 21 سنتيمتراً. ثم قامت بشل حركة زبونة، وأحدثت لها جرحاً لا يقل عن 10 سم على مستوى حلقها توقف «على بعد بضعة مليمترات من الأوعية الدموية الكبيرة»، على ما جاء في لائحة الاتهام. وصرخت
تريد سويسرا المهددة بأزمة طاقة مثل الدول الأوروبية الأخرى، خفض استهلاكها من الغاز بنسبة 15 في المائة هذا الشتاء، كما أعلنت الحكومة السويسرية التي حذت بذلك حذو الاتحاد الأوروبي. وقال المجلس الاتحادي السويسري (الحكومة) في بيان، أمس الأربعاء، إن «سويسرا يجب أن تسهم الآن مثل البلدان الأخرى، في تجنب حالة نقص في الغاز قدر الإمكان عبر اتخاذ إجراءات طوعية»، لأن غزو روسيا لأوكرانيا هز بقوة قطاع الطاقة. والهدف هو خفض الطلب على الغاز الذي تستورد سويسرا كل حاجاتها منه، بنسبة 15 في المائة خلال فصل الشتاء من أكتوبر (تشرين الأول) 2022 إلى نهاية مارس (آذار) 2023 عن متوسط الاستهلاك خلال السنوات الخمس الماضية.
اكتشف العلماء أول مادة فيزيائية على الإطلاق قادرة على «تذكر» تاريخها الكامل من المحفزات الفيزيائية، على غرار تلك الموجودة في الدماغ. عثر فريق كلية البوليتكنيك الفيدرالية في لوزان (EPFL) في سويسرا على هذه الخاصية الرائعة أثناء بحثهم في المرحلة الانتقالية لثاني أكسيد الفاناديوم (في أوه 2)، وهو مركب يستخدم في الإلكترونيات، وفقاً لصحيفة «إندبندنت». كان طالب الدكتوراه محمد ساميزاده نيكو يحاول معرفة المدة التي يستغرقها «في أوه 2» للانتقال من حالة إلى أخرى، لكنه سرعان ما أدرك أن شيئاً لم يسبق له مثيل كان يحدث عند تطبيق تيار كهربائي. وقال نيكو: «تحرك التيار عبر المادة، متبعاً مساراً حتى خرج على الجانب
عُثر في نهر جليدي على حطام طائرة سقطت قبل أكثر من 54 سنة، في الجانب السويسري من جبال الألب عام 1968، على ما أعلنت الشرطة، أول من أمس (الجمعة). ورُصدت بقايا الطائرة على نهر أليتش الجليدي، جنوب غربي كانتون فاليه، قرب قمتي يونغفراو ومونك.
أصدرت اللجنة الدولية للصليب الأحمر تحذيراً عاجلاً بشأن زيادة عدد الأشخاص الذين يعانون من الجوع على مستوى العالم. وحذرت اللجنة الدولية أمس (الثلاثاء) من أن أفريقيا وحدها بها حوالي 346 مليون شخص ليس لديهم ما يكفي من الغذاء، بما يمثل ربع سكان القارة، وفقاً لوكالة الأنباء الألمانية. وقال روبرت مارديني الأمين العام للجنة الدولية للصليب الأحمر: «نواجه وضعاً طارئاً وسريع التدهور فيما يتعلق بالأمن الغذائي العالمي، خصوصاً في أنحاء من أفريقيا والشرق الأوسط.
صنفت وحدة الاستخبارات الاقتصادية التابعة لمجموعة «الإيكونيميست» في مؤشرها السنوي، العاصمة النمساوية فيينا بوصفها المدينة الأكثر ملاءمة للعيش في العالم، بعد أن تصدرت المدينة القائمة في عامي 2018 و2019. وفي العام الماضي، انخفض تقييم نوعية الحياة في المدن الأوروبية بشكل كبير بسبب عمليات الإغلاق وغيرها من قيود «كورونا» المعمول بها في جميع أنحاء القارة، في حين وضعت الأنشطة التجارية في نيوزيلندا كالمعتاد مدينة أوكلاند على رأس القائمة، وفقاً لوكالة الأنباء الألمانية. ورغم ذلك، ومع رفع معظم قيود «كورونا» في أماكن أخرى من العالم مطلع العام الجاري، شهدت مدن في نيوزيلندا وأستراليا والصين تراجعا إلى قاع ا
تعقد منظمة الصحة العالمية اجتماعا للخبراء اليوم (الخميس)، وذلك لتقييم ما إذا كان ينبغي اعتبار انتشار جدري القردة «حالة طوارئ صحية عامة تثير قلقا دوليا»، وفقاً لوكالة الأنباء الألمانية. وسيدرس الخبراء المستقلون ما إذا كان العالم بحاجة إلى إصدار تحذير بشأن التهديد الصحي المتزايد، ومن غير المتوقع أن تصدر نتائج هذه المداولات قبل يوم غد (الجمعة). يشار إلى أن إعلان حالة طوارئ صحية عالمية ليس له عواقب عملية فورية بخلاف جعل الحكومات والشعوب أكثر يقظة. وأعلنت منظمة الصحة العالمية أن فيروس «كورونا» المستجد حالة طوارئ صحية عامة عالمية في 30 يناير (كانون الثاني) عام 2020. وتتألف لجنة جدري القردة بمنظمة ال
قالت منظمة الصحة العالمية إنها ستعيد تسمية فيروس جدري القردة لتجنب التمييز، مع استمرار انتشار المرض بين الناس بشكل غير مسبوق، وفقاً لصحيفة «الغارديان». وأوضح الدكتور تيدروس أدهانوم غيبريسوس، المدير العام لمنظمة الصحة العالمية، إنهم «يعملون مع شركاء وخبراء من جميع أنحاء العالم لتغيير اسم فيروس جدري القردة، وتكتلاته، والمرض الذي يسببه». وتأتي هذه الخطوة بعد أن دعا العلماء إلى تغيير «عاجل» للاسم الذي وصفوه بأنه «غير دقيق» و«تمييزي» وبمثابة «وصم»، في تقرير صدر الأسبوع الماضي.
أحصت المفوضية السامية للأمم المتحدة لشؤون اللاجئين 100 مليون شخص في جميع أنحاء العالم أجبروا على الفرار من ديارهم، وهو أعلى عدد من النازحين يسجل منذ الحرب العالمية الثانية، وفقاً لوكالة الأنباء الألمانية. وقالت المفوضية في تقرير الاتجاهات العالمية الذي صدر اليوم (الخميس) إن نزوح المدنيين من أوكرانيا هو أكبر وأسرع أزمة لاجئين نمواً، منذ تأسيس المفوضية السامية للأمم المتحدة لشؤون اللاجئين في عام 1951. وأضافت المفوضية ومقرها جنيف أن الغزو الروسي لأوكرانيا كان من بين حالات الطوارئ المتزامنة المتعددة، إلى جانب الغزو في أفغانستان، مما دفع الرقم إلى أكثر من 100 مليون. وحذر المفوض السامي للأمم المتحدة
أعلنت خدمة المراقبة الجوية «سكايغايد» المجموعة السويسرية لخدمات الملاحة الجوية، اليوم (الأربعاء)، «إعادة فتح» المجال الجوي لهذه الدولة الواقعة في جبال الألب السويسرية، بعد أن توقفت الرحلات الجوية بالكامل بسبب عطل معلوماتي استمر لساعات، وفقاً لوكالة الصحافة الفرنسية. وأوضحت المجموعة في تغريدة: «تم حل المشكلة الفنية في (سكايغايد) ورفع إغلاق المجال الجوي وأُعيد فتح المجال الجوي السويسري واستؤنفت الرحلات الجوية فوق سويسرا وفي مطاري جنيف وزيوريخ كذلك»، من دون تحديد سبب العطل.
قالت وكالة «سكاي غايد» لخدمات الملاحة الجوية إن مشكلة فنية في نظام مراقبة الحركة الجوية أوقفت الإقلاع والهبوط بالمطارات السويسرية، وفقاً لوكالة «رويترز». وذكرت في بيان: «تعرضت (سكاي غايد) لخدمات الملاحة الجوية السويسرية لعطل فني في الساعات الأولى من صباح اليوم، ولهذا جرى إغلاق المجال الجوي السويسري أمام حركة الملاحة لاعتبارات السلامة». وأضافت أن «إغلاق المجال الجوي يسري حتى إشعار آخر». وقالت «سكاي غايد» إنها تعمل على إيجاد حل. كان متحدث باسم مطار زيوريخ قد قال في وقت سابق إن عمليات الإقلاع والهبوط توقفت، في حين ذكر مطار جنيف على «تويتر» أن حركة المرور لن تُستأنف قبل الساعة الثامنة صباحاً (06:0
أفادت الحملة الدولية لإلغاء الأسلحة النووية (آيكان) في تقرير أن القوى النووية زادت نفقاتها لتحديث ترساناتها الذرية بحوالي 9 في المائة خلال العام 2021 وصولا إلى نفقات إجمالية قدرها 82.4 مليار دولار، وفقاً لوكالة الصحافة الفرنسية. وذكرت الحملة في تقرير أصدرته اليوم (الثلاثاء) أن الولايات المتحدة وحدها أنفقت 44.2 مليار دولار على برنامجها النووي العام الماضي، بزيادة 12.7 في المائة عن العام السابق، فيما خصصت الصين 11.7 مليار دولار بزيادة 10.4 في المائة لبرنامجها النووي. كذلك أفادت آيكان الحائزة جائزة نوبل للسلام عام 2017 على عملها من أجل التوصل إلى معاهدة الأمم المتحدة لحظر الأسلحة النووية التي أبر
لم تشترك بعد
انشئ حساباً خاصاً بك لتحصل على أخبار مخصصة لك ولتتمتع بخاصية حفظ المقالات وتتلقى نشراتنا البريدية المتنوعة